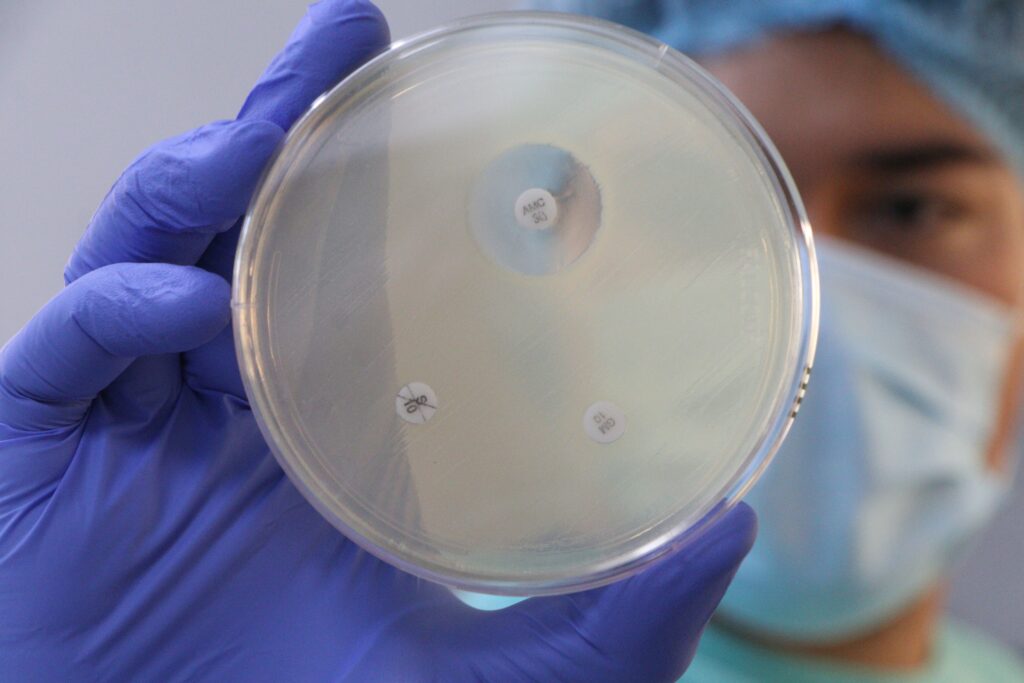
Llaman al uso responsable de medicamentos veterinarios

Especialistas del Senasica, UNAM y Cibnor alertan que la Resistencia a los Antimicrobianos pone en riesgo la salud animal, humana, ambiental y la seguridad alimentaria
Llaman al uso responsable de medicamentos veterinarios
La Secretaría de Agricultura y Desarrollo Rural (AGRICULTURA), a través del Servicio Nacional de Sanidad, Inocuidad y Calidad Agroalimentaria (Senasica), hizo un llamado al sector productivo y a la población en general a sumarse a los esfuerzos mundiales para desalentar el uso indiscriminado de medicamentos antibióticos, antivirales, antifúngicos y antiparasitarios, con el fin de evitar la Resistencia a los Antimicrobianos (RAM).
AGRICULTURA se sumó a la Semana Mundial de Concientización sobre la Resistencia a los Antimicrobianos (WAAW, por sus siglas en inglés), que se llevó a cabo del 18 al 24 de noviembre, con el objetivo de sensibilizar a médicas y médicos veterinarios, productoras y productores pecuarios y a la sociedad en general, sobre los efectos adversos del mal uso de estos fármacos.
La Resistencia a los Antimicrobianos es ocasionada, principalmente, por el uso indiscriminado de antimicrobianos, lo que provoca que las bacterias se hagan resistentes y sean más difíciles de combatir. La edición 2025 de la Semana Mundial sobre la RAM tiene como lema: “Actuemos ya: protejamos nuestro presente, aseguremos nuestro futuro”.
Durante dos días de actividades en la Unidad Integral de Servicios, Diagnóstico y Constatación (UISDC) del Senasica, especialistas del organismo, de la Universidad Nacional Autónoma de México (UNAM) y del Centro de Investigaciones Biológicas del Noroeste (Cibnor) impartieron ponencias magistrales e intercambiaron experiencias sobre la importancia de que toda la población se una a la lucha contra la RAM.
Coincidieron en la necesidad de exponer, cada vez en más foros, el riesgo que implica el uso indiscriminado de estos medicamentos para la salud de los animales de consumo y de compañía, así como su repercusión en la salud pública y en el medio ambiente.
Durante la inauguración del evento, el coordinador del Subcomité de RAM en Salud Animal (SCRAM-V), Carlos Jasso Villazul, subrayó que la resistencia a los antimicrobianos es una amenaza sanitaria creciente, de ahí la importancia de mantenerla en las agendas públicas a nivel mundial.
Añadió que este fenómeno tiene repercusiones en la salud de los ecosistemas, la productividad y la economía, y es uno de los principales factores que ponen en riesgo la seguridad alimentaria de México y del mundo.
Precisó que el Plan de Acción Integral —en el cual participa Senasica— tiene el objetivo de promover el uso responsable de antimicrobianos en unidades de producción de animales terrestres y acuáticos, para reducir la presencia de bacterias patógenas resistentes. Incluye acciones específicas como la supervisión diagnóstica y la vigilancia epidemiológica.
En representación de la UISDC, el especialista del Centro Nacional de Servicios de Diagnóstico en Salud Animal (Cenasa), Emilio Venegas Cureño, destacó que este complejo, ubicado en Tecámac, Estado de México, es reconocido desde hace cinco años como Centro de Referencia de la Organización de las Naciones Unidas para la Alimentación y la Agricultura (FAO) para la resistencia a los antimicrobianos.
Recordó que este reconocimiento, que sólo tienen países como Reino Unido, Dinamarca, Tailandia, Alemania, Estados Unidos y Francia, ha permitido fortalecer la Estrategia Nacional contra la RAM que lleva a cabo el Gobierno de México, mediante un trabajo que involucra a diversas instancias federales.

Por su parte, especialistas de la Dirección de Sanidad Acuícola y Pesquera del Senasica destacaron que, en ese sector, es frecuente la medicación sin diagnóstico confirmatorio de enfermedad, ya que la mayoría de los fármacos se suministran durante la alimentación de los animales acuáticos.
Coincidieron en que el uso de vacunas autógenas —biológicos personalizados que se utilizan para generar inmunidad específica contra la cepa local de un patógeno— es una herramienta eficaz para prevenir infecciones y, en consecuencia, reducir significativamente el uso de antimicrobianos.
La edición 2025 de la WAAW, impulsada por la Organización Mundial de Sanidad Animal (OMSA), la Organización Mundial de la Salud (OMS), la FAO y el Programa de las Naciones Unidas para el Medio Ambiente (PNUMA), convoca a la sociedad en general a cumplir el lema: “Actuemos ya: protejamos nuestro presente, aseguremos nuestro futuro”.



